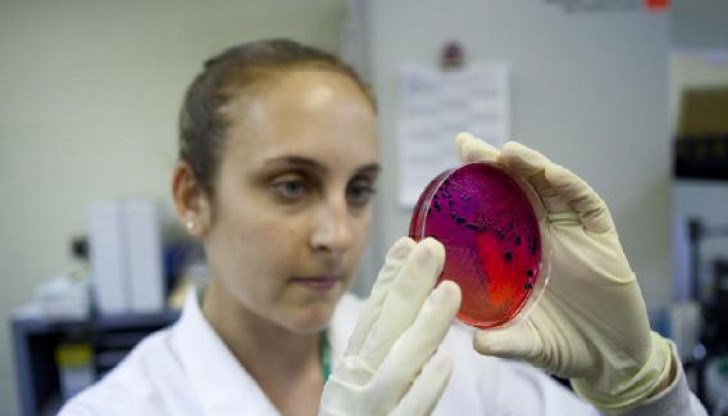

Учени откриха нови смъртоносни бактерии
- Редактор: Диляна Маринова
- Коментари: 0
Според доклад на експертите от Центъра за контрол и превенция на заболяванията (CDC) в Съединените щати през м.г. са били открити 221 нови случаи на инфекции.
Те са били причинени от бактерии, устойчиви на всички или повечето от антибиотиците. Статията е публикувана в списанието Vital Signs, предава Zdrave.to.
Според доклада поне един от 10 души, които не са имали симптоми на болестта, са се оказали носители на поне една суперинфекция в лечебни заведения, където са открити антибиотично устойчиви микроорганизми.
Тези микроби имат гени за имунитет за лекарства, които могат да бъдат предавани на други бактерии. По този начин здравите хора могат да бъдат скрити преносители на смъртоносни болести.
Първият заместник-директор на CDC Ан Шукет, цитирана от USA today обясни: "Необходимо е да се положат допълнителни усилия и ние трябва да действаме по-бързо и по-рано."
Според нея всяка четвърта проба, насочена към анализиране на бактериите, съдържа специални гени, които позволяват на микроорганизмите да разпространяват устойчивост към други бактерии. При всеки десети случай хората, заразени с тези бактерии, разпространяват инфекцията сред здрави хора в болници.
В публикувания доклад се препоръчва служители на лечебни заведения да провеждат бърз анализ на микроорганизми, в който се подозира резистентност към антибиотици. В допълнение, експертите на CDC пишат, трябва да се определят тези, които може да бъдат носители на суперинфекция, и да се следи за пациенти, които са били прехвърлени в други болници.





















МВР променя спешно наредбите за пътна безопасност
Учители готвят ефективна национална стачка
Ренета Колева стана заместник-министър на околната среда
Учители готвят ефективна национална стачка
Слави Трифонов: Господин Демерджиев, няма да спра да Ви...